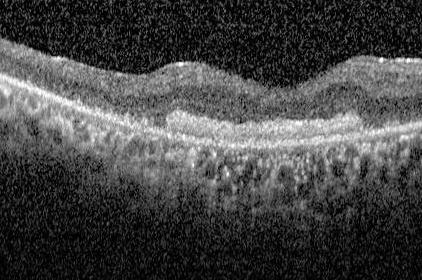

三十八歲吳先生因巨大黃斑部裂孔致視力嚴重下降,二度接受手術皆未能成功治癒。二零二二年底,吳先生經親友介紹,輾轉至花蓮慈濟醫院眼科何明山醫師門診求醫,經檢查發現黃斑部裂孔已達2100微米(µm),何明山醫師判定常規治療方式可能無法使裂孔癒合,查閱國外文獻後,創全臺首例突破療法,利用高濃度血小板血漿(platelet-rich plasma, PRP)為吳先生做增生治療。術後三個月,2100微米的巨大黃斑部裂孔已完整癒合,吳先生感激表示:「何醫師是我黑暗中的明燈,不僅還給我視力,也讓我看見希望!」
「這是我行醫生涯至今看過黃斑部裂孔最大的患者,也可能這輩子只會遇到這一位。」何明山醫師指出,一般黃斑部裂孔大小約400微米,若超過800微米就算是很大的破洞了;過去他在臨床上遇到的最大裂孔約1000微米,因此看到吳先生2100微米裂孔的檢測數據後,也感到相當驚訝和棘手。居住在高雄的吳先生,先前於當地醫院接受手術時,醫師曾為了填補孔洞,在眼膜中置放了一小片人工羊膜,但因破洞實在太大,在手術隔天檢查時就發現羊膜已移位。
何明山醫師表示,若同樣使用傳統標準的手術方式,很可能會讓吳先生再遭遇第三次手術的失敗,加上黃斑部的破洞若無法癒合,會隨時間越變越大;為了尋找更合適的治療方案,在多方查找文獻資料並和吳先生討論後,何醫師決定以高濃度血小板血漿(platelet-rich plasma, PRP)治療。PRP增生治療是將患者的血液離心後,將分離出的生長因子注射到患部,促進血管新生或組織修復,一般常用於肌腱、韌帶、關節的退化或損傷;在此之前,臺灣尚無眼疾利用PRP手術治療的前例,僅在國外有極少數黃斑部裂孔大小超過2000微米且以PRP治療成功的案例。
何明山醫師於去年十二月初為吳先生開刀,先將移位的羊膜補回原本的破洞位置,再打進高濃度血小板血漿,幫助裂孔修復,經過四個月的修養,吳先生的黃斑部已初步癒合,視力也獲得極大的改善。
吳先生感恩何明山醫師成為他「黑暗中的明燈」,表示自己四年前開始發現右眼有點奇怪,到三年前第一次治療、二年前第二次治療,症狀每況愈下,裂孔從1600微米變成2000微米,甚至因為代償使用導致左眼視力也急遽下滑,也已引發嚴重的焦慮;經友人介紹,特地從高雄到花蓮慈院尋求何明山醫師的幫助,感恩何醫師的不懈的努力與突破性的嘗試,自己才有這次「重見光明」的機會。

▲手術前的光學電腦斷層掃描圖顯示,吳先生的黃斑部裂孔已達2100微米。
▲手術後的光學電腦斷層掃描圖可見黃斑部裂孔已癒合。

▲花蓮慈院何明山醫師創全臺首例突破療法,利用高濃度血小板血漿(PRP)為吳先生的巨大黃斑部裂孔做增生治療。